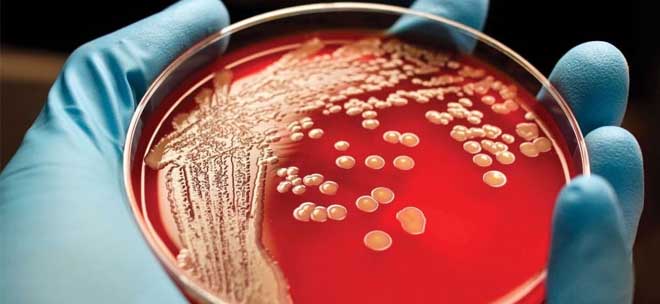

Κάθε Σεπτέμβριο, ο μήνας ευαισθητοποίησης για τον καρκίνο του αίματος (αιματολογικές κακοήθειες) χρησιμεύει ως μια σημαντική στιγμή για να στραφεί το ενδιαφέρον σε μια ομάδα καρκίνων που επηρεάζουν το αίμα, τον μυελό των οστών και το λεμφικό σύστημα. Οι αιματολογικές κακοήθειες, συμπεριλαμβανομένων της λευχαιμίας, του λεμφώματος και του πολλαπλού μυελώματος, επηρεάζουν εκατομμύρια ανθρώπους παγκοσμίως. Κι όμως, συχνά παραμένουν εκτός της ευρύτερης συζήτησης για τον καρκίνο.
Αυτός ο μήνας αποτελεί ευκαιρία για να ευαισθητοποιηθούμε, να υποστηρίξουμε τους ασθενείς και τους οικείους τους και να αναδείξουμε την ανάγκη για περισσότερη έρευνα και πόρους για την ανάπτυξη νέων θεραπειών, όπως αναφέρει ο Θάνος Δημόπουλος (τ. Πρύτανης ΕΚΠΑ, Καθηγητής Θεραπευτικής – Ογκολογίας – Αιματολογίας, Διευθυντής Θεραπευτικής Κλινικής της Ιατρικής Σχολής του ΕΚΠΑ, Νοσοκομείο Αλεξάνδρα), παραθέτοντας ορισμένα στοιχεία:
Ο καρκίνος του αίματος είναι ένας όρος που περιλαμβάνει διάφορους τύπους καρκίνων που επηρεάζουν τα λευκά αιμοσφαίρια, τον μυελό των οστών και το λεμφικό σύστημα. Οι πιο συχνοί τύποι είναι η λευχαιμία, το λέμφωμα και το πολλαπλούν μυέλωμα. Καθένας από αυτούς τους καρκίνους συμπεριφέρεται διαφορετικά και απαιτεί διαφορετικές θεραπευτικές προσεγγίσεις:
Λευχαιμία
Επηρεάζει τον μυελό των οστών και το αίμα, οδηγώντας στην παραγωγή ανώμαλων λευκών αιμοσφαιρίων που παρεμποδίζουν την ικανότητα του σώματος να καταπολεμά τις λοιμώξεις. Η λευχαιμία μπορεί να είναι οξεία (οξεία λεμφοβλαστική λευχαιμία, οξεία μυελογενής λευχαιμία) ή χρόνια (χρόνια λεμφοκυτταρική λευχαιμία, χρόνια μυελογενής λευχαιμία), ενώ υπάρχουν και σπανιότερες εκφάνσεις της νόσου όπως η χρόνια μυελομονοκυτταρική λευχαιμία, η λευχαιμία εκ τριχωτών κυττάρων και άλλες.
Η θεραπευτική προσέγγιση εξατομικεύεται ανάλογα με τον υπότυπο της λευχαιμίας και μπορεί να περιλαμβάνει συνδυασμό χημειοθεραπευτικών παραγόντων και ανοσοθεραπεία. Αξίζει να σημειωθεί ότι σε ορισμένους τύπους λευχαιμίας, όπως η οξεία λεμφοβλαστική, που είναι ανθεκτική σε προηγούμενες θεραπείες έχει λάβει έγκριση η θεραπεία με Τ-λεμφοκύτταρα που φέρουν έναν χιμαιρικό υποδοχέα αντιγόνου (CAR Τ-λεμφοκύτταρα) με σημαντική βελτίωση του προσδόκιμου και της ποιότητας ζωής των ασθενών.
Λέμφωμα
Ξεκινάει στο λεμφικό σύστημα, το οποίο αποτελεί κρίσιμο μέρος του ανοσοποιητικού συστήματος. Προκαλεί ανώμαλη ανάπτυξη των λεμφοκυττάρων, ενός τύπου λευκών αιμοσφαιρίων, και μπορεί να επεκταθεί σε διάφορα μέρη του σώματος. Υπάρχουν πολλοί διαφορετικοί τύποι και υπότυποι λεμφώματος ανάλογα με το αν έχουν επιθετική ή αργή εξέλιξη και αν προέρχονται από Β ή Τ λεμφοκύτταρα.
Οι νεότερες ανοσοθεραπείες με CAR Τ-λεμφοκύτταρα και με αμφι-ειδικά αντισώματα έχουν βελτιώσει σημαντικά τα αποτελέσματα των ασθενών με υποτροπιάζον/ανθεκτικό λέμφωμα. Για παράδειγμα, το epcoritamab οδηγεί σε βαθιές και παρατεταμένες ανταποκρίσεις σε ασθενείς με υποτροπιάζων ή ανθεκτικό λέμφωμα από μεγάλα Β-κύτταρα (DLBCL), που έχουν λάβει 2 ή περισσότερες γραμμές θεραπείας με διαχειρίσιμη τοξικότητα. Το mosunetuzumab αποτελεί πλέον θεραπευτική επιλογή για τους ασθενείς με υποτροπιάζον ή ανθεκτικό οζώδες λέμφωμα μετά από τουλάχιστον 2 προηγούμενες γραμμές θεραπείας. Ο αναστολέας επόμενης γενιάς της BTK, pirtobrutinib, έχει δείξει αποτελεσματικότητα και αποτελεί πλέον επιλογή και για τους ασθενείς με λέμφωμα μανδύα και ανθεκτική/υποτροπιάζουσα νόσο.
Στο λέμφωμα Hodgkin τα τελευταία χρόνια έχει ενταχθεί στη θεραπεία το κλασικό σχήμα AVD (χωρίς μπλεομυκίνη) σε συνδυασμό με το brentuximab vedotin, ένα συζευγμένο μονοκλωνικό αντίσωμα με φάρμακο, στην πρώτη γραμμή θεραπείας, ενώ ο συνδυασμός nivolumab-AVD φαίνεται να υπερέχει και είναι πιθανό να αποτελέσει σύντομα την πρώτη θεραπευτική επιλογή για τους ασθενείς αυτούς.
Πολλαπλούν μυέλωμα
Αρχίζει στα πλασματοκύτταρα, έναν άλλο τύπο λευκών αιμοσφαιρίων που βρίσκονται στον μυελό των οστών, διαταράσσοντας την κανονική παραγωγή αντισωμάτων και καθιστώντας το σώμα πιο ευάλωτο σε λοιμώξεις. Σήμερα, η συντριπτική πλειονότητα των ασθενών ανταποκρίνεται στην αρχική θεραπευτική αγωγή και σε πολλούς ασθενείς η νόσος μένει σε ύφεση για μεγάλο χρονικό διάστημα. Αρκετές όμως φορές, τα κακοήθη κύτταρα του μυελώματος αποκτούν ανθεκτικότητα στη θεραπευτική αγωγή με το χρόνο και η νόσος υποτροπιάζει. Το υποτροπιάζον ή/και ανθεκτικό πολλαπλούν μυέλωμα μετά από πολλαπλές γραμμές θεραπευτικής αγωγής αποτελεί πραγματική πρόκληση για τους κλινικούς ιατρούς.
Οι νεότερες ανοσοθεραπείες όπως τα Τ-λεμφοκύτταρα που φέρουν χιμαιρικό αντιγονικό υποδοχέα (chimeric antigen receptor – CAR) και τα αμφι-ειδικά (bispecific) αντισώματα έχουν ενταχθεί στη θεραπευτική φαρέτρα και βελτιώνουν την πρόγνωση και την ποιότητα ζωής των ασθενών. Τα συγκεκριμένα φάρμακα αξιολογούνται επίσης σε κλινικές μελέτες με σκοπό να χορηγούνται πρωιμότερα και να βελτιστοποιήσουν τα ποσοστά μακροχρόνιας ύφεσης μετά την θεραπεία πρώτης γραμμής.
Η σημασία της ευαισθητοποίησης του κοινού
Η ευαισθητοποίηση για τις αιματολογικές κακοήθειες είναι ζωτικής σημασίας για διάφορους λόγους.
- Πρώτον, οι καρκίνοι του αίματος συχνά παρουσιάζουν ασαφή ή μη ειδικά συμπτώματα όπως κόπωση, πυρετό, νυχτερινές εφιδρώσεις, ανεξήγητη απώλεια βάρους ή διογκωμένους λεμφαδένες. Αυτά τα συμπτώματα μπορεί εύκολα να παρερμηνευτούν ως άλλες, λιγότερο σοβαρές καταστάσεις, οδηγώντας σε καθυστερημένη διάγνωση και θεραπεία. Η αύξηση της ευαισθητοποίησης μπορεί να ενθαρρύνει τους ανθρώπους να αναζητήσουν ιατρική συμβουλή νωρίτερα, εντοπίζοντας πιθανώς την ασθένεια στα πρώτα της στάδια, όταν είναι δυνητικά θεραπεύσιμη.
- Δεύτερον, οι καρκίνοι του αίματος παραμένουν ένα σημαντικό ζήτημα δημόσιας υγείας. Σύμφωνα με την Leukemia & Lymphoma Society, οι καρκίνοι του αίματος αντιπροσωπεύουν σχεδόν το 10% όλων των νέων διαγνώσεων καρκίνου κάθε χρόνο στις Ηνωμένες Πολιτείες Αμερικής. Παγκοσμίως, εκατομμύρια άνθρωποι ζουν με αυτούς τους καρκίνους, αλλά η χρηματοδότηση και οι πόροι που αφιερώνονται στην έρευνα για τον καρκίνο του αίματος υπολείπονται αυτών που διατίθενται για πιο γνωστούς καρκίνους, όπως ο καρκίνος του μαστού ή του πνεύμονα.
 Health Update Health Update
Health Update Health Update